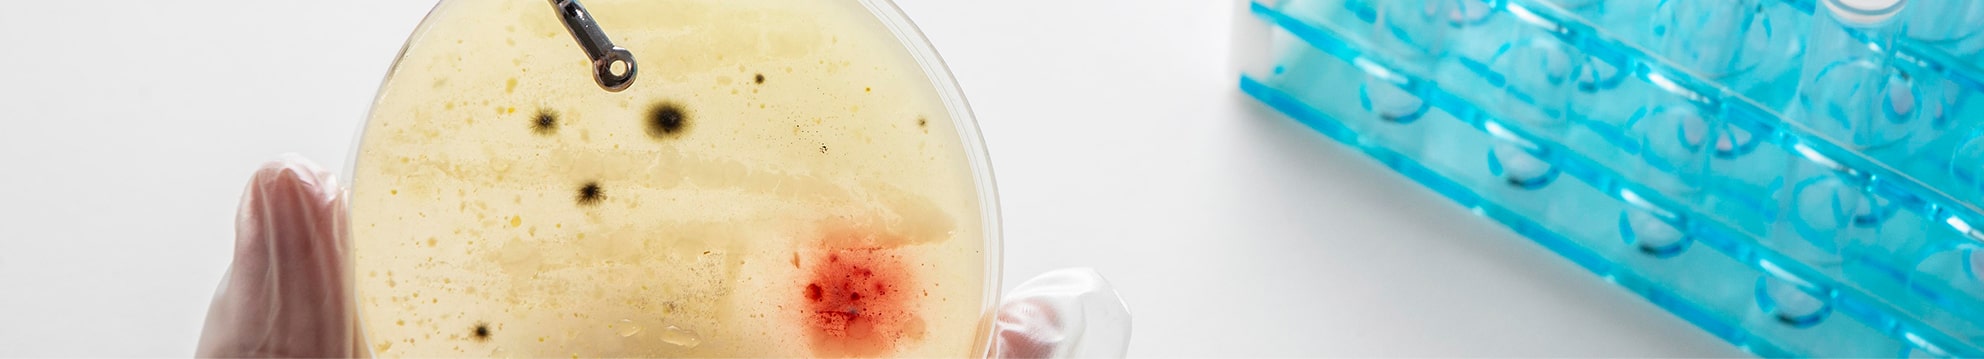
Ovi Clinic Augmented Medicine Diagnostic Tools Genomic Analyses

Offer more precise, more human and more personalized medicine.

About us
Founded in Geneva in 2021, OVI Clinic was born from the meeting of doctors, specialists and therapists who share the same vision: to combine their skills to offer comprehensive, personalized, patient-centered care. We offer a new generation of preventive and collaborative medicine. At OVI Clinic, we believe in the power of the collective, in constant dialogue between disciplines, and in a deep commitment to the well-being of each individual.
OVI Clinic combines precision medicine, scientifically-validated complementary approaches and the latest technologies to offer you comprehensive, sustainable health.

Our name, OVI,
reflects our vision: Optimize. Vitalize. Integrate.
Three words that guide every course of treatment.

The Clinic
A new approach to healthcare
Located in the heart of Geneva, on the 1st floor of 118 Rue du Rhône, OVI Clinic offers an easily accessible setting designed to welcome every patient in the best possible conditions.
The clinic brings together :
- 5 doctors’ surgeries
- 3 treatment rooms
- 1 surgery operating room, for safe outpatient procedures.
- An integrated UNILABS sampling center, guaranteeing immediate access to reliable, high-quality analyses.
Our priority has been to create an environment where medical precision and human attention come together. Each space has been designed to promote a fluid, reassuring and respectful care experience, in the image of the medicine we advocate: demanding, integrative and sustainable.


Our method
What is integrative medicine?
Optimization, Complementarity, Synergy, Customization.
A holistic approach that enriches conventional medicine with rigorous, scientifically-proven complementary therapies. The aim is to understand your state of health and act on the root causes, while promoting prevention and longevity.
Add life to years, not years to life.
Frequent reasons for consultation
Prostate, kidney, bladder and testicular cancer
Benign prostatic hyperplasia associated with urinary disorders
Lithiasis
(urinary calculi)
Recurrent urinary tract infections (cystitis, prostatitis…)
Andrological disorders:
erectile and ejaculatory dysfunction
Chronic pelvic pain
Neurological mictional disorders (incontinence, blockage)
Pelvic floor disorders
Male fertility disorders
Urological check-up
At OVI CLINIC, multidisciplinarity is applied as an organized and coherent integration. Our approach is based on 6 founding principles:
Here, we don’t dream of tomorrow’s medicine. We’re building it: predictive, preventive, personalized and participatory. Every act of care is part of an informed decision, and every patient is an active partner.
Our vision
Prevent, treat and sustainably optimize your health.
Vitalize your longevity potential.
Our Values
They are the foundation of every decision, every care, every relationship. They are the expression of our commitment to making medicine more demanding, more accurate and more meaningful. They guide our integrative approach, our professional ethics and the quality of our relationships with our patients.
Humility
It is a driving force for continuous improvement and healthy relationships, both with patients and within the team. It means knowing how to surround ourselves with competent professionals, both internal and external, to ensure optimal care. By applying this rigorous ethical principle, we guarantee trust and responsibility.
Innovation
At the forefront of medical developments related to health and longevity, redefining tomorrow’s healthcare standards. Innovation is the answer to our constant quest for improvement.
Excellence
We pursue the highest standards of medicine. Our rigorous approach is based on the expertise of specialists in their field, precision diagnostics and treatments based on the latest medical and scientific advances.
Empathy
Human relations are at the heart of our vision. It permeates both patient care and the relationships between our employees. We cultivate an environment based on listening, caring and mutual respect, convinced that the development of each individual is essential to the quality of care and the collective vitality of our clinic.
Integration
Combining the excellence of conventional and integrative medicine to offer optimized global care: physical, mental and functional.
Augmented medicine
Technology in the service of health.
We invest in cutting-edge diagnostic and therapeutic technologies to deliver precision medicine and longevity.
Thanks to state-of-the-art diagnostic tools, we can map your health in a precise and targeted way, so that we can act earlier and more precisely.
Diagnostic tools
1 High-tech imaging

2 Genomic analysis
3 In-depth functional assessments

4 Medical AI

5 Performance biomarkers

Innovative therapeutic technologies
1 Resum

2 Bioresonance

3 Radiofrequency

4 Photobiomodulation

5 Neurofeedback

6 Orthomolecular therapies

7 Cellular therapies

Committed experts, a team united by high standards
Doctors, surgeons, therapists, nurses and medical and administrative assistants combine their skills to offer coherent, seamless, personalized care.
A demanding collaboration, guided by ethics, excellence and attention to people.

The OVI CLINIC Manifesto
By Dr. Guillaume Altwegg, Founder and Managing Director
OVI Clinic was created around a clear and demanding ambition:
to bring together, in one place, the scientific rigor of modern medicine and the depth of an evidence-based integrative approach.
Our vision stems from a simple belief: medicine must understand before it acts.
It must prevent as much as it treats, and protect health over the long term.
Its purpose is not only to treat disease, but to identify the underlying causes of symptoms and imbalances.
Today, medical science offers a level of precision that was unimaginable just a few years ago. We can diagnose, measure, and deliver care with remarkable precision. Yet precision only becomes meaningful when it is grounded in a holistic view of the patient’s health — their history, their results, their lifestyle, and their environment.
At OVI Clinic, this comprehensive and personalised understanding is what guides our vision of care.
From this observation arises our mission: to prevent, treat, and optimise health at every stage of life.
We are committed to a form of medicine that is grounded in clinical practice, enriched by research, and continuously open to innovation — a medicine that is precise, personalised, and adapted to each individual.
Our approach is built on three pillars: Optimise. Vitalise. Integrate.
To optimise means anticipating, understanding, and strengthening.
It means detecting imbalances before they evolve into disease, sharpening diagnosis, tailoring treatment, and extending healthy, active years — the healthspan.
To vitalise means supporting the body’s essential functions.
Restoring energy, sleep, mental clarity, hormonal balance, and reinforcing immunity — the body’s innate ability to adapt and protect itself.
Health is not static; it is cultivated daily through movement, nutrition, recovery, and stress regulation.
To integrate means bringing worlds together.
Combining the rigor of conventional medicine with complementary practices supported by evidence.
Fostering dialogue between disciplines, aligning expertise, and placing the patient at the center.
This philosophy shaped the design of OVI CLINIC: a place where physicians and therapists work together, share knowledge, and broaden one another’s practice. Because working together allows us to provide care that is more precise and better suited to each patient.
This same standard guides our surgical and interventional practices.
Mastery of minimally invasive techniques is part of our core expertise.
It reflects a modern, precise form of medicine that respects tissues and prioritises recovery.
Reducing surgical trauma, pain, complications, and hospital stay; accelerating healing and return to function — this is the promise of minimally invasive care.
Whenever appropriate, choosing a minimally invasive approach means acting with accuracy, efficiency, and respect for the body.
At OVI Clinic, every decision, every gesture, and every innovation serves one purpose: to deliver care that is appropriate, safe, and truly supportive of the patient’s long-term health.
We believe in preventive, personalised, and predictive;
in medicine that listens, that is precise, and that builds trust;
in medicine that uses technology without being defined by it, that unites science with the reality of care, and that progresses each day alongside the people it serves.
OVI Clinic — Optimize. Vitalize. Integrate.
Because extending life is not enough.
Our commitment: “Add life to years, not just years to life.”
